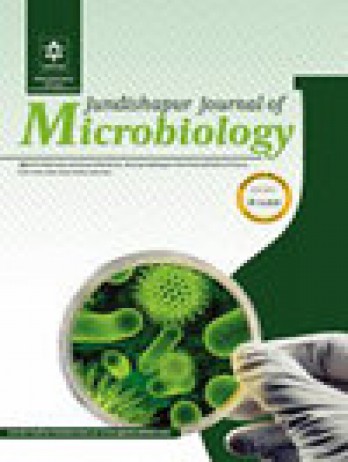

《Jundishapur Journal Of Microbiology》雜志拒稿后是可以轉投其他期刊的, 但需要注意以下幾點:
一、確認拒稿狀態:在轉投之前,作者必須確保文章確實已被《Jundishapur Journal Of Microbiology》雜志拒稿。如果尚未收到明確的拒稿通知,建議耐心等待或主動向雜志社詢問審稿進度和結果。
二、修改論文:根據審稿意見修改論文,確保解決提出的問題,并改進論文的結構、方法、論證等方面。
三、轉刊操作建議
優先選擇同出版社期刊?:Kowsar Publishing Company旗下其他醫學雜志可能更易接收。?
選擇匹配度更高的期刊:參考JCR分區、影響因子、收稿方向,避免因“主題不符”再次被拒。
附修改說明?:轉投時建議提交針對前次拒稿意見的改進說明,提升通過率。
四、注意事項
避免一稿多投,保持耐心和信心。
《Jundishapur Journal Of Microbiology》雜志概括
國際標準簡稱:JUNDISHAPUR J MICROB
創刊時間:2008年
出版商:Kowsar Publishing Company
出版周期:Monthly
出版語言:English
出版地區:NETHERLANDS
ISSN:2008-3645,E-ISSN:2008-4161
收錄數據庫:SCIE
學科領域:MICROBIOLOGY(MICROBIOLOGY)
期刊定位:專注于發表微生物學領域的文章,旨在為研究人員提供該領域的最新研究成果和前沿動態。
《Jundishapur Journal Of Microbiology》雜志審稿周期預計為: 較慢,6-12周 ,年發文量:約71篇,H-index:20。
《Jundishapur Journal Of Microbiology》雜志數據
(1)影響因子
該雜志的影響因子為0.5,在微生物學領域具有較高的學術影響力。
(2)分區情況
中科院分區:
大類學科:醫學4區。
小類學科:MICROBIOLOGY微生物學4區。
JCR分區:
按JIF指標學科分區分區:Q4區; 按JCI指標學科分區分區:Q4區;
(3)CiteScore
CiteScore數值為1.3,( 小類學科:MICROBIOLOGY,分區為Q4,百分位:22%。小類學科:MICROBIOLOGY,分區為Q4,百分位:16%。)
聲明:本信息依據互聯網公開資料整理,若存在錯誤,請及時聯系我們及時更正。